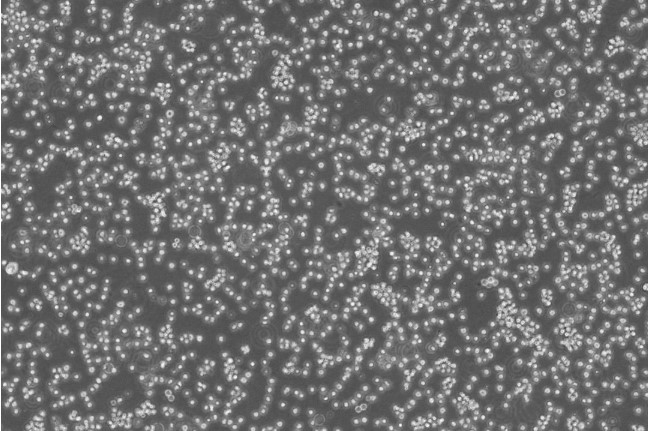
TOLEDO Cells人弥漫大B细胞淋巴瘤悬浮细胞系(提供全部细胞STR鉴定图谱)

"TOLEDO Cells人弥漫大B细胞淋巴瘤悬浮细胞系(提供全部细胞STR鉴定图谱)
传代比例:1:2-1:4(首次传代建议1:2)
背景信息:详见相关文献介绍
┈订┈购(技术服务)┈热┈线:1┈3┈6┈4┈1┈9┈3┈0┈7┈9┈1【微信同号】┈Q┈Q:3┈1┈8┈0┈8┈0┈7┈3┈2┈4;
COLO-680N Cells;背景说明:详见相关文献介绍;传代方法:1:2-1:3传代;每周换液2-3次。;生长特性:贴壁或悬浮,详见产品说明书部分;形态特性:详见产品说明书;相关产品有:HEK-293FT细胞、KP 4细胞、HGSMC细胞
L cell line Cells;背景说明:详见相关文献介绍;传代方法:1:2-1:3传代;每周换液2-3次。;生长特性:贴壁或悬浮,详见产品说明书部分;形态特性:详见产品说明书;相关产品有:IBMF-7细胞、Hs839T细胞、SUM102PT细胞
HFF Cells;背景说明:详见相关文献介绍;传代方法:1:5—1:7传代;生长特性:贴壁生长;形态特性:成纤维细胞;相关产品有:MAEC细胞、HuH 6细胞、P3.653细胞
MIMVEC Cells;背景说明:肠粘膜微血管;内皮 Cells;传代方法:1:2-1:3传代;每周换液2-3次。;生长特性:贴壁;形态特性:详见产品说明书;相关产品有:A2780细胞、CCLP1细胞、SW-780细胞
换液周期:每周2-3次
为什么培养的细胞要及时传代?体外培养的细胞大多具有生长接触抑制的性,也就是说当一个细胞被其他细胞包围的时候,它就会停止生长,及时传代后,细胞的生长得以继续。培养细胞生长减慢的原因在哪些?其解决办法有哪些?可能的原因有:更换了不同的培养或血清;培养中一些细胞生长必需成分如谷眈肢或生长因子等耗尽或缺乏或己被破坏;培养物中有少量细菌或真菌污染;试剂保存不当;比较新培养与原培养成分,比较新血清与旧血清等,找出其它可能的原因。解决办法:增加起始培养细胞浓度;让细胞逐渐适应新培养;换入新鲜配制培养;补加谷酷肢或生长因子等;用无抗生素培养培养,如发现污染,去弃培养物,或用抗生素除菌;血清需保存在5℃到20℃; 培养需在2-8℃避光保存;含血清完全培养在2-8℃保存,并在2周内用完;分离培养物,检测支原体。冷冻管应如何解冻?取出冷冻管后,须立即放入37℃水槽中快速解冻,轻摇冷冻管使其在1-2分钟内大部分融化,别注意,需残留一小块冰块,就可拿到超净工作台操作细胞,用75%酒精消毒冻存管,用新鲜培养基将细胞转移至培养瓶。另外冷冻管由桶中取出解冻时,必须注意安全,预防冷冻管爆裂。
TOLEDO Cells人弥漫大B细胞淋巴瘤悬浮细胞系(提供全部细胞STR鉴定图谱)
生长特性:悬浮生长
产品包装:复苏发货:T25培养瓶(一瓶)或冻存发货:1ml冻存管(两支)
C-26 Cells;背景说明:详见相关文献介绍;传代方法:1:2-1:3传代;每周换液2-3次。;生长特性:贴壁或悬浮,详见产品说明书部分;形态特性:详见产品说明书;相关产品有:NCI-SNU-878细胞、NS-1-Ag4-1细胞、J-774A.1细胞
TCC-PAN2 Cells;背景说明:详见相关文献介绍;传代方法:1:2-1:3传代;每周换液2-3次。;生长特性:贴壁或悬浮,详见产品说明书部分;形态特性:详见产品说明书;相关产品有:Suzhou Human Glioma-44细胞、LMH细胞、IOSE-Van细胞
Madin Darby Canine Kidney Cells;背景说明:详见相关文献介绍;传代方法:1:2传代;生长特性:贴壁生长 ;形态特性:详见产品说明书;相关产品有:M20 [Human melanoma]细胞、SK-MEL5细胞、TM-4细胞
BERH-2 Cells;背景说明:肝癌;传代方法:1:2-1:3传代;每周换液2-3次。;生长特性:贴壁;形态特性:详见产品说明书;相关产品有:MM1-S细胞、HL-7702细胞、Roswell Park Memorial Institute 2650细胞
┈订┈购(技术服务)┈热┈线:1┈3┈6┈4┈1┈9┈3┈0┈7┈9┈1【微信同号】┈Q┈Q:3┈1┈8┈0┈8┈0┈7┈3┈2┈4;
来源说明:细胞主要来源ATCC、ECACC、DSMZ、RIKEN等细胞库
接收细胞相关问题:如不能在收到细胞后及时操作细胞,25及离心管发货的细胞将可以消毒后在37度过夜,血清发货的细胞在室温下静置1-2天(注意不要放冰箱),干冰发货的可以在确认干冰未完全升华时将细胞直接放回或者-80度冰箱,若干冰完全升华,请即刻复苏细胞。25瓶及离心管在培养箱平衡是为了让细胞尽快适应培养箱环境,同时使部分因运输导致脱落的细胞贴壁,此步骤非常必要。25瓶如果在显微镜下可以看到部分不贴壁的细胞,可以收集上清后离心(1200rpm,5min)后,将沉淀用新的培养基重悬后接种至新的培养瓶或皿中。部分细胞在运输过程中,由于不断震荡及环境不适,可能导致细胞破碎死亡,从而使培养基中漂浮很多细胞碎片及颗粒状物质。这种情况下,平衡后,贴壁细胞用PBS洗两遍再加新的培养基培养或者传代至新瓶中培养即可;悬浮细胞可以离心(1000rpm,3min)收集细胞,并用PBS重悬后再离心一次,再用新的培养基重悬并接种细胞。
物种来源:人源、鼠源等其它物种来源
TOLEDO Cells人弥漫大B细胞淋巴瘤悬浮细胞系(提供全部细胞STR鉴定图谱)
形态特性:淋巴母细胞样
在细胞培养操作中,每一个步骤都可能影响细胞系的命运。有时,细胞换液后突然死亡,这让科研人员困惑不已。那么,究竟是什么原因导致了这种情况呢?首先,换液操作过程中的不当处理是一个常见因素。例如,使用的移液器如果没有校准准确,吸取或添加培养液的量过多或过少,都可能使细胞所处的环境渗透压发生变化。细胞在渗透压失衡的环境中,水分子会快速进出细胞,导致细胞肿胀或皱缩,最终死亡。此外,如果在吸取旧培养液时过于靠近细胞层,容易造成细胞的机械性损伤,破坏细胞的完整性,使其无法维持正常的生理功能。其次,培养液的成分和质量也至关重要。新配制的培养液若在成分比例上出现偏差,如某些营养物质浓度过高或过低,可能无法满足细胞的生长需求,导致细胞因营养缺乏或中毒而死亡。而且,培养液若在储存或处理过程中受到污染,从而迅速致使细胞死亡。再者,培养环境的变化不容忽视。换液时,比如,温度过高会使细胞内蛋白质变性,温度过低则会降低细胞的活性和代谢速率;二氧化碳浓度的改变会影响培养液的酸碱度,进而干扰细胞的正常生理活动。所以细胞换液后死亡是多种因素综合作用的结果。
Abcam HCT 116 MST1R KO Cells(提供STR鉴定图谱)
AG07801 Cells(提供STR鉴定图谱)
BayGenomics ES cell line CSJ301 Cells(提供STR鉴定图谱)
BayGenomics ES cell line TEA140 Cells(提供STR鉴定图谱)
BL-9 Cells(提供STR鉴定图谱)
CLGL-90 Cells(提供STR鉴定图谱)
DA03475 Cells(提供STR鉴定图谱)
ESC/LCM20T-N Cells(提供STR鉴定图谱)
GM06945 Cells(提供STR鉴定图谱)
HeLa-229 Cells;背景说明:宫颈癌;女性;传代方法:1:2-1:3传代;每周换液2-3次。;生长特性:贴壁;形态特性:详见产品说明书;相关产品有:HEK 293T/17细胞、HSC-5 [Human skin squamous cell carcinoma]细胞、SP2/0 Ag-14细胞
NB9 Cells;背景说明:详见相关文献介绍;传代方法:1:10 1:50每2 - 3周;每周换液2-3次。;生长特性:贴壁生长;形态特性:成神经细胞;相关产品有:WM451细胞、A-9细胞、MPC11细胞
NCI-H1734 Cells;背景说明:详见相关文献介绍;传代方法:1:4-1:6传代。;生长特性:贴壁生长;形态特性:上皮细胞样;相关产品有:IEC-6细胞、SKO-007细胞、RPE1细胞
38C-13 Cells;背景说明:B淋巴瘤;C3H/eB;传代方法:1:2-1:3传代;每周换液2-3次。;生长特性:半贴壁;形态特性:详见产品说明书;相关产品有:MAVER细胞、HT-3细胞、U343细胞
Balb/c3T3 Cells;背景说明:胚胎;成纤维;自发永生;雄性;BALB/c;传代方法:1:2-1:3传代;每周换液2-3次。;生长特性:贴壁;形态特性:详见产品说明书;相关产品有:IPLB-SF 21AE细胞、DLM8细胞、BL6细胞
MPC-83 Cells;背景说明:胰腺;腺泡 Cells;传代方法:1:2-1:3传代;每周换液2-3次。;生长特性:贴壁;形态特性:详见产品说明书;相关产品有:PL9细胞、MC 116细胞、H1355细胞
MLM Cells;背景说明:急性粒白血病;传代方法:1:2-1:3传代;每周换液2-3次。;生长特性:悬浮;形态特性:详见产品说明书;相关产品有:NCI-H1581细胞、NPA-87细胞、GM03320D细胞
HCC-1438 Cells;背景说明:详见相关文献介绍;传代方法:1:2-1:3传代;每周换液2-3次。;生长特性:贴壁或悬浮,详见产品说明书部分;形态特性:详见产品说明书;相关产品有:LN229细胞、PA I细胞、BpRcl细胞
High 5 Cells;背景说明:详见相关文献介绍;传代方法:1:2-1:3传代;每周换液2-3次。;生长特性:贴壁或悬浮,详见产品说明书部分;形态特性:详见产品说明书;相关产品有:PANC 327细胞、MA104细胞、MKN7细胞
PANC0813 Cells;背景说明:详见相关文献介绍;传代方法:1:2传代;生长特性:贴壁生长;形态特性:上皮样;相关产品有:293c18细胞、P3/ag细胞、BRL-3A细胞
Madin Darby Bovine Kidney Cells;背景说明:详见相关文献介绍;传代方法:1:2传代;生长特性:贴壁生长 ;形态特性:详见产品说明书;相关产品有:LU65细胞、JB6 [Mouse]细胞、H1623细胞
TE-85 clone 5 Cells;背景说明:骨肉瘤;女性;传代方法:1:2-1:3传代;每周换液2-3次。;生长特性:贴壁;形态特性:详见产品说明书;相关产品有:TE6细胞、MRC-5细胞、FT-293细胞
UMUC-14 Cells;背景说明:肾癌;男性;传代方法:1:2-1:3传代;每周换液2-3次。;生长特性:贴壁;形态特性:详见产品说明书;相关产品有:HCAEC细胞、NS-20Y细胞、CTLL2细胞
GLC-82 Cells;背景说明:详见相关文献介绍;传代方法:1:2-1:3传代;每周换液2-3次。;生长特性:贴壁或悬浮,详见产品说明书部分;形态特性:详见产品说明书;相关产品有:C2C12细胞、NCI-H292细胞、1E8-H细胞
H-2052 Cells;背景说明:详见相关文献介绍;传代方法:1:3-1:6传代;生长特性:贴壁生长;形态特性:上皮细胞;相关产品有:SUM149-PT细胞、SCL II细胞、Hs 863.T细胞
AR41P Cells;背景说明:详见相关文献介绍;传代方法:1:3-1:6传代;每周2-3次。;生长特性:贴壁生长;形态特性:上皮细胞样;相关产品有:SW527细胞、P3/X63/Ag8.653细胞、EC-GI-10细胞
AR41P Cells;背景说明:详见相关文献介绍;传代方法:1:3-1:6传代;每周2-3次。;生长特性:贴壁生长;形态特性:上皮细胞样;相关产品有:SW527细胞、P3/X63/Ag8.653细胞、EC-GI-10细胞
TOLEDO Cells人弥漫大B细胞淋巴瘤悬浮细胞系(提供全部细胞STR鉴定图谱)
EAC Cells;背景说明:艾氏腹水瘤;传代方法:1:2-1:3传代;每周换液2-3次。;生长特性:半贴壁;形态特性:详见产品说明书;相关产品有:U-373 MG细胞、Acanthosis Nigricans 3rd attempt-CArcinoma细胞、Swiss-3T3细胞
Hs 729 Cells;背景说明:详见相关文献介绍;传代方法:1:2传代;每周换液2-3次。;生长特性:贴壁生长;形态特性:成纤维细胞;相关产品有:SK Hep1细胞、YES-2细胞、JB-6 Cl 30细胞
293T/17 Cells;背景说明:胚肾;5型腺病毒及SV40转化;女性;传代方法:1:2-1:3传代;每周换液2-3次。;生长特性:贴壁;形态特性:详见产品说明书;相关产品有:SU-DHL-16细胞、IPEC1细胞、H1693细胞
HMO6 Cells;背景说明:小胶质 Cells;传代方法:1:2-1:3传代;每周换液2-3次。;生长特性:贴壁;形态特性:详见产品说明书;相关产品有:NG 108-15细胞、CNE2Z细胞、H-378细胞
HMC-1 Cells;背景说明:肥大 Cells;传代方法:1:2-1:3传代;每周换液2-3次。;生长特性:悬浮;形态特性:详见产品说明书;相关产品有:ML-2细胞、NCI-H711细胞、H35 Reuber细胞
NT2D1 Cells;背景说明:详见相关文献介绍;传代方法:1:2-1:3传代;每周换液2-3次。;生长特性:贴壁或悬浮,详见产品说明书部分;形态特性:详见产品说明书;相关产品有:GAK细胞、NL20SV细胞、D10细胞
┈订┈购(技术服务)┈热┈线:1┈3┈6┈4┈1┈9┈3┈0┈7┈9┈1【微信同号】┈Q┈Q:3┈1┈8┈0┈8┈0┈7┈3┈2┈4;
Reuber H35 Cells;背景说明:在糖皮质激素、胰岛素或cAMP衍生物的诱导下可以产生酪酸基转移酶;可被逆转录病毒感染;可产生白蛋白、转铁蛋白、凝血酶原;在AxC大鼠中可以成瘤。;传代方法:1:2传代;生长特性:贴壁生长;形态特性:上皮样;相关产品有:TC-1[JHU-1]细胞、M-1 myeloid leukemia细胞、JM细胞
Hs737T Cells;背景说明:详见相关文献介绍;传代方法:1:2—1:3传代;每周换液2-3次;生长特性:贴壁生长;形态特性:成纤维细胞;相关产品有:KLN 205细胞、MDAMB468细胞、HA细胞
COV504 Cells;背景说明:详见相关文献介绍;传代方法:1:2传代;生长特性:贴壁生长;形态特性:上皮细胞;相关产品有:H341细胞、Rh30细胞、Hs 27细胞
QBI-HEK 293A Cells;背景说明:胚肾;腺病毒包装;传代方法:1:2-1:3传代;每周换液2-3次。;生长特性:贴壁;形态特性:详见产品说明书;相关产品有:EU-2细胞、MN9D细胞、CHAGOK1细胞
P3J HR-1 Cells;背景说明:详见相关文献介绍;传代方法:每2-3天换液;生长特性:悬浮生长 ;形态特性:淋巴母细胞样;相关产品有:GM02219C细胞、NCI.H23细胞、MDA-MB-231-luc细胞
SW1353 Cells;背景说明:骨肉瘤;女性;传代方法:1:2-1:3传代;每周换液2-3次。;生长特性:贴壁;形态特性:详见产品说明书;相关产品有:GP293细胞、L5178Y细胞、CAL-51细胞
GU2092 Cells(提供STR鉴定图谱)
HAP1 PRKCE (-) 3 Cells(提供STR鉴定图谱)
HG01269 Cells(提供STR鉴定图谱)
HUES 48 Cells(提供STR鉴定图谱)
L alpha Cells(提供STR鉴定图谱)
MS215 Cells(提供STR鉴定图谱)
OCUM-8/5-FU Cells(提供STR鉴定图谱)
RN Cells(提供STR鉴定图谱)
SYSUSCi004-A Cells(提供STR鉴定图谱)
Ubigene HeLa SHFL KO Cells(提供STR鉴定图谱)
XP41OS Cells(提供STR鉴定图谱)
ALT Cells(提供STR鉴定图谱)
SK.MEL.2 Cells;背景说明:详见相关文献介绍;传代方法:1:3-1:6传代,2-3天换液1次。;生长特性:贴壁生长;形态特性:多边形的;相关产品有:Strain KB细胞、NIH-3T3-L1细胞、95-D细胞
A-375SM Cells;背景说明:黑色素瘤;女性;传代方法:1:2-1:3传代;每周换液2-3次。;生长特性:贴壁;形态特性:详见产品说明书;相关产品有:HCa/16A3-F细胞、NCIH1355细胞、NR8383细胞
SUM 52 Cells;背景说明:乳腺癌;胸腔积液转移;女性;传代方法:1:2-1:3传代;每周换液2-3次。;生长特性:贴壁;形态特性:详见产品说明书;相关产品有:MDA415细胞、SU86-86细胞、SKRC-20细胞
H-847 Cells;背景说明:详见相关文献介绍;传代方法:1:2-1:3传代;每周换液2-3次。;生长特性:贴壁或悬浮,详见产品说明书部分;形态特性:详见产品说明书;相关产品有:Li-7细胞、ATDC-5细胞、CMECs细胞
NS1-1 Ag4.1 Cells;背景说明:这是P3X63Ag8(ATCCTIB-9)的一个不分泌克隆。Kappa链合成了但不分泌。能抗0.1mM8-氮杂鸟嘌呤但不能在HAT培养基中生长。据报道它是由于缺失了3-酮类固醇还原酶活性的胆固醇营养缺陷型。检测表明肢骨发育畸形病毒(鼠痘)阴性。;传代方法:1:2传代,3天内可长满。;生长特性:悬浮生长;形态特性:淋巴母细胞;相关产品有:H-1238细胞、PANC1005细胞、EB3 [Human Burkitt lymphoma]细胞
LAC Cells;背景说明:肺癌;传代方法:1:2-1:3传代;每周换液2-3次。;生长特性:贴壁;形态特性:详见产品说明书;相关产品有:SGC 7901细胞、CFSC-8B细胞、Panc 5.04细胞
BE(2)-M17 Cells;背景说明:详见相关文献介绍;传代方法:1:2-1:3传代;每周换液2-3次。;生长特性:贴壁或悬浮,详见产品说明书部分;形态特性:详见产品说明书;相关产品有:H-774细胞、A2780细胞、beta-TC6细胞
HPAF Cells;背景说明:详见相关文献介绍;传代方法:1:2-1:3传代;每周换液2-3次。;生长特性:贴壁或悬浮,详见产品说明书部分;形态特性:详见产品说明书;相关产品有:Hs 729细胞、SKMEL-24细胞、SNK1细胞
ECC-1 Cells;背景说明:内膜腺癌;女性;传代方法:1:2-1:3传代;每周换液2-3次。;生长特性:贴壁;形态特性:详见产品说明书;相关产品有:3T3 Swiss Albino细胞、Neuro2a细胞、H2126细胞
MCM Cells;背景说明:心肌;传代方法:1:2-1:3传代;每周换液2-3次。;生长特性:贴壁;形态特性:详见产品说明书;相关产品有:P-36细胞、C3H 10T1/2细胞、MFE280细胞
38C13 Cells;背景说明:B淋巴瘤;C3H/eB;传代方法:1:2-1:3传代;每周换液2-3次。;生长特性:半贴壁;形态特性:详见产品说明书;相关产品有:YH细胞、P31-FUJ细胞、Tn5 B1-4细胞
U-937 Cells;背景说明:该细胞是由NilssonK实验室于1974年从一名37岁的患有恶性组织细胞性淋巴瘤的白人男性的胸水中分离建立的。1979年来的研究显示该细胞在人混合淋巴细胞培养物上清、佛波酯、VitD3、γ-IFN、TNF和维A酸的诱导下可以向终末单核细胞分化。该细胞不合成免疫球蛋白,EBV阴性;可产生溶菌酶、β-2-微球蛋白,受PMA刺激后可产生TNF-α;表达C3R;可作转染宿主;表达Fas,对TNF和抗Fas的抗体敏感。;传代方法:维持细胞浓度在1×105-2×106/ml;根据细胞浓度3-4换液1次。;生长特性:悬浮生长;形态特性:单核细胞;相关产品有:MPC 11细胞、JM细胞、Epstein-Barr-2细胞
BHK-21 Cells;背景说明:详见相关文献介绍;传代方法:1:2传代,每周换液1-2次。;生长特性:贴壁生长;形态特性:成纤维细胞样;相关产品有:QGP 1细胞、U266-B1细胞、SUM-190细胞
NCI-H1355 Cells;背景说明:详见相关文献介绍;传代方法:每周换液2次。;生长特性:悬浮生长;形态特性:详见产品说明书;相关产品有:NCI-H1618细胞、COLO-1细胞、T 24细胞
U-138MG Cells;背景说明:星形细胞瘤;男性;传代方法:1:2-1:3传代;每周换液2-3次。;生长特性:贴壁;形态特性:详见产品说明书;相关产品有:NS-20Y细胞、PC-9S1细胞、HFTF细胞
BC3H1 Cells;背景说明:详见相关文献介绍;传代方法:1:2-1:3传代;每周换液2-3次。;生长特性:贴壁或悬浮,详见产品说明书部分;形态特性:详见产品说明书;相关产品有:T9细胞、OC 316细胞、NS-20Y细胞
RIN m5F Cells;背景说明:胰岛β细胞瘤;雄性;NEDH;传代方法:1:2-1:3传代;每周换液2-3次。;生长特性:贴壁;形态特性:详见产品说明书;相关产品有:H-2141细胞、ROS-17/2.8细胞、SF 295细胞
R-1059-D Cells;背景说明:骨肉瘤;女性;传代方法:1:2-1:3传代;每周换液2-3次。;生长特性:贴壁;形态特性:详见产品说明书;相关产品有:DanG细胞、C41细胞、RBL-1细胞
IPLB-SF 21AE Cells;背景说明:详见相关文献介绍;传代方法:1:2-1:3传代;每周换液2-3次。;生长特性:贴壁或悬浮,详见产品说明书部分;形态特性:详见产品说明书;相关产品有:SKO3细胞、Intestinal Porcine Epithelial Cell line-J2细胞、HCC-2108细胞
CCRF/CEM/0 Cells;背景说明:G.E. Foley 等人建立了类淋巴母细胞细胞株CCRF-CEM。 细胞是1964年11月从一位四岁白人女性急性淋巴细胞白血病患者的外周血白血球衣中得到。此细胞系从香港收集而来。;传代方法:1:2传代。3天内可长满。;生长特性:悬浮生长;形态特性:淋巴母细胞样;相关产品有:H9c2(2-1)细胞、HCC-1419细胞、H661细胞
SW-48 Cells;背景说明:1971-1975年间,A. Leibovitz从结肠腺癌中分离建立十个细胞系,SW48为为其中之一。该细胞合成癌胚抗原,能在裸鼠中成瘤。;传代方法:1:3传代,2-3天传一代;生长特性:贴壁生长;形态特性:上皮细胞样;相关产品有:COLO 16细胞、H-2030细胞、B16 F1细胞
L929 Cells;背景说明:详见相关文献介绍;传代方法:1:2-1:3传代;每周换液2-3次。;生长特性:贴壁或悬浮,详见产品说明书部分;形态特性:详见产品说明书;相关产品有:NCI-H1792细胞、HuCC-T1细胞、293 EBNA细胞
Hs606T Cells;背景说明:详见相关文献介绍;传代方法:1:2—1:3传代,2—3天换液一次;生长特性:贴壁生长;形态特性:成纤维细胞;相关产品有:FL-83B细胞、H322细胞、HCC2935细胞
RKO-AS45-1 Cells;背景说明:详见相关文献介绍;传代方法:1:2-1:3传代;每周换液2-3次。;生长特性:贴壁或悬浮,详见产品说明书部分;形态特性:详见产品说明书;相关产品有:HCC0827细胞、MDA-MB-468-RED细胞、OCI Ly19细胞
MAntle cell VERona-1 Cells;背景说明:详见相关文献介绍;传代方法:1:3-1:5传代;2-3天换液1次。;生长特性:悬浮生长;形态特性:淋巴母细胞;相关产品有:CORL88细胞、PASMCS细胞、Tu686细胞
NCIH727 Cells;背景说明:详见相关文献介绍;传代方法:每周换液2次。;生长特性:贴壁生长;形态特性:详见产品说明书;相关产品有:NCI-N87细胞、TN5B14细胞、SW1573细胞
3D4/21 Cells;背景说明:肺泡巨噬细胞;SV40转化;Landrace;传代方法:1:2-1:3传代;每周换液2-3次。;生长特性:贴壁;形态特性:详见产品说明书;相关产品有:32D CL3细胞、MNNG/HOS Cl #5细胞、TFH细胞
TOLEDO Cells人弥漫大B细胞淋巴瘤悬浮细胞系(提供全部细胞STR鉴定图谱)
TK 10 Cells;背景说明:详见相关文献介绍;传代方法:1:3-1:6传代;2-3天换液1次。;生长特性:贴壁生长;形态特性:上皮样;相关产品有:MC-116细胞、AG06814-N细胞、CAL851细胞
SUM190 Cells;背景说明:乳腺癌;女性;传代方法:1:2-1:3传代;每周换液2-3次。;生长特性:贴壁;形态特性:详见产品说明书;相关产品有:SW 780细胞、JURKAT E-61细胞、SCC15细胞
Tca-8113 Cells;背景说明:舌鳞癌;女性;传代方法:1:2-1:3传代;每周换液2-3次。;生长特性:贴壁;形态特性:详见产品说明书;相关产品有:KM12细胞、Hca-F细胞、NP-69细胞
IOSE-80 Cells;背景说明:卵巢;上皮细胞;SV40转化;女性;传代方法:1:2-1:3传代;每周换液2-3次。;生长特性:贴壁;形态特性:详见产品说明书;相关产品有:mouse Inner Medullary Collecting Duct-3细胞、LO2细胞、H1781细胞
NCIH1703 Cells;背景说明:该细胞1987年建系,源自一位54岁患有非小细胞肺癌的白人男性,该患者为吸烟者。;传代方法:1:3—1:6传代,每周换液2—3次;生长特性:贴壁生长;形态特性:上皮细胞样;相关产品有:NK-10A细胞、Hs 683细胞、A-172MG细胞
SKN-SH Cells;背景说明:SK-N-SH细胞系由J.L.Bieder建系,它与SK-N-MC所不同的是倍增时间较长且多巴胺-β-羟基酶水平较高。 SK-N-SH在细胞介导的细胞毒性试验中用作靶细胞系。;传代方法:1:2传代;生长特性:悬浮生长;形态特性:上皮细胞样;相关产品有:Hs606细胞、GOS-3细胞、B16-F0细胞
Hepa1-6 Cells;背景说明:此细胞株源自C57/L小鼠中引发的BW7756肝癌;表达AFP、α1抗胰蛋白酶、淀粉酶;鼠痘病毒阴性。此细胞可以在无血清的培养基中繁殖,培养基成分是:DMEM,75%;Waymouth'sMAB87/3培养基,25%。添加3x10-8M。;传代方法:1:2传代;生长特性:贴壁生长;形态特性:上皮样;相关产品有:Dx5细胞、H-1522细胞、Panc 5.04细胞
Hs 729.T Cells;背景说明:详见相关文献介绍;传代方法:1:2传代;每周换液2-3次。;生长特性:贴壁生长;形态特性:成纤维细胞;相关产品有:H-820细胞、H-2141细胞、UCLA RO-81A-1细胞
┈订┈购(技术服务)┈热┈线:1┈3┈6┈4┈1┈9┈3┈0┈7┈9┈1【微信同号】┈Q┈Q:3┈1┈8┈0┈8┈0┈7┈3┈2┈4;
Lewis lung carcinoma line 1 Cells;背景说明:详见相关文献介绍;传代方法:1:2-1:3传代;每周换液2-3次。;生长特性:贴壁或悬浮,详见产品说明书部分;形态特性:详见产品说明书;相关产品有:MDA157细胞、A431/P细胞、MCF-7B细胞
WEHI 3B Cells;背景说明:白血病;BALB/c;传代方法:1:2-1:3传代;每周换液2-3次。;生长特性:悬浮;形态特性:详见产品说明书;相关产品有:H-1882细胞、LoMeT-ccRcc细胞、H-1930细胞
RIN-14B Cells;背景说明:胰岛素瘤;雄性;NEDH;传代方法:1:2-1:3传代;每周换液2-3次。;生长特性:贴壁;形态特性:详见产品说明书;相关产品有:UO.31细胞、HLE-SRA-01/04细胞、MT-2J细胞
BayGenomics ES cell line RRN094 Cells(提供STR鉴定图谱)
BayGenomics ES cell line YHA129 Cells(提供STR鉴定图谱)
H1L1.1c7 Cells(提供STR鉴定图谱)
P3G8 Cells(提供STR鉴定图谱)
Ab92 Cells(提供STR鉴定图谱)
HOB1/VCR0.1 Cells(提供STR鉴定图谱)
"